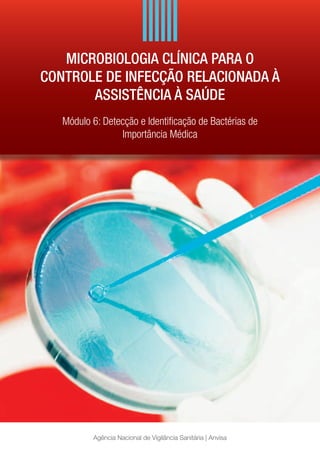

PDF) A IMPORTÂNCIA DA Salmonella spp. NA INTERAÇÃO AMBIENTE-HOMEM
Por um escritor misterioso
Last updated 28 março 2025


PDF) Microbiologia Clínica, Ambiental e Alimentos

Revista RG News Vol. 8 N°2 2022 by Sociedade Brasileira de

08 Agosto BRF Rural - andressa.silva - Page 1 - 22

Salmonella: informações importantes que você precisa saber

PDF) A IMPORTÂNCIA DO FERRO (FE) E COBRE (CU) PARA A MINERAÇÃO NO

Collection and Processing of Lymph Nodes from Large Animals for

PDF) Zoonoses emergentes e reemergentes e sua importância para

PDF) Evaluation of activity lithic of virulent bacteriophages in

Importância do microbioma intestinal no bem estar animal - Blog
Microbiologia_clinica_ANVISA__

Salmonella lcqa - Fármacia

PDF) ESTUDO DA TOXICIDADE E ATIVIDADE ANTIFUNGICA DE Lantana

PDF) Salmonella spp. como agente causal em Doenças Transmitidas

792 3016-2-pb

Microbiologia do Solo - 2ª edição by Araunah Agro - Issuu
Recomendado para você
-
⚽ (@DoentesPFutebol) / X28 março 2025
-
Doentes por Futebol vira sucesso na rede28 março 2025
-
Doentes por Futebol - 4 anos atrás, o Google nos impossibilitou de continuar a deixar nossos gabaritos em nossa comunidade do Orkut. Bons tempos.28 março 2025
-
Doentes Por Futebol28 março 2025
-
O que você gostava no futebol, mas não existe mais? : r/futebol28 março 2025
-
Santos vai estrear na Libertadores dia 9 de março. Veja o caminho - Diário do Peixe28 março 2025
-
Imigrantes da Bola (podcast) - Imigrantes da Bola28 março 2025
-
Midget famoso Las Vegas28 março 2025
-
Tenho uma franga de freguês! - O Maior de Minas28 março 2025
-
Esperança Reeditada: Cordel4928 março 2025
você pode gostar
-
Dragon Age: Origins - Image #100028 março 2025
-
E-GIFT CARD28 março 2025
-
Play FNF Indie Cross V1 Mod Online for Free on PC & Mobile28 março 2025
-
Gay furry hackers' breach nuclear lab, demand it create catgirls28 março 2025
-
What's even the point of this devil fruit : r/MemePiece28 março 2025
-
The HP Victus Ryzen Edition RTX 4060 Gaming Laptop Is Only $999.9928 março 2025
-
Arthur Rubinstein Competition Winners Concert28 março 2025
-
Where do u guys get bully for Android now? Since it doesn't support newer versions of Android for some reason : r/bully28 março 2025
-
Nes no Brasil28 março 2025
-
Memes em imagens ACADEMIAS EM 2023 💪 #shorts28 março 2025